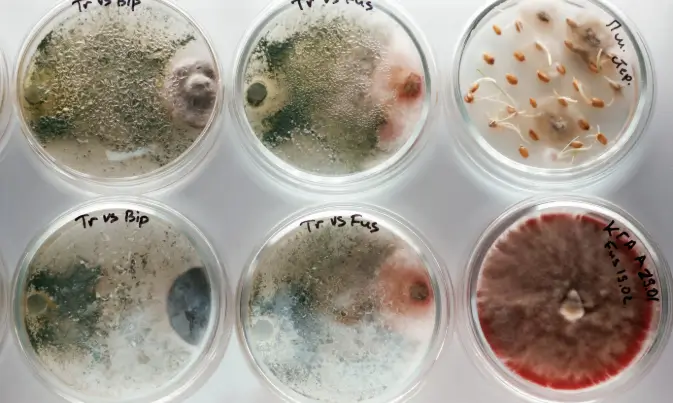

Pathology & Laboratory
Our laboratory operates in accordance with ISO 15189 standards, ensuring quality-controlled processes and dependable results. We are staffed by experienced Medical Laboratory Scientists and supported by automated systems to provide comprehensive testing across multiple disciplines.


Immunology
We provide advanced immunoassay testing for immune function, hormonal studies, tumor markers, and infectious disease evaluation, supported by automated platforms for consistent performance.
Haematology
We perform comprehensive blood analysis including full blood counts and related investigations, using automated analyzers to deliver reliable hematologic assessment.

Microbiology
Our microbiology laboratory handles culture, organism identification, and sensitivity testing conducted in controlled laboratory conditions to ensure dependable microbial analysis.
Chemicopathology
We offer comprehensive Biochemical investigations including kidney function, liver function, lipid profile, glucose studies, and electrolyte analysis, etc processed through automated chemistry systems.


Serology
Our serology services include Infectious disease screening, blood grouping, genotype testing, and immune response evaluation using standardized and automated methodologies.
Pathology & Laboratory FAQs
I need to do a fasting blood sugar test. What is the procedure?
Fasting: Do not eat or drink anything except water for 8–12 hours before your test.
Timing: Please arrive at the laboratory before 10:00 AM to ensure your sample is collected within the optimal window.
Medication: If you take regular medication, please check with your physician beforehand whether you should take it on the morning of the test.
Sample Collection: A phlebotomist will draw a blood sample from a vein in your arm.
After the test: You may eat and drink immediately. You may wish to bring a snack to have after your blood is drawn.
I want to do a hormonal profile. When is the best time for this?
Day 2 of your cycle: This is typically for assessing baseline ovarian function, including FSH, LH, and Estradiol levels. Day 1 of your cycle is counted as the first day of full menstrual flow.
And
Day 21 of your cycle: This is typically for assessing ovulation and progesterone levels. Your physician will specify which date applies based on the information they require.
Why is timing important for the horrmonal profile test?
Hormone levels fluctuate throughout the menstrual cycle. Performing the test on specific days allows your physician to accurately assess different phases of your cycle and identify potential imbalances.
I want to do a pap smear, how do I prepare?
Schedule the test before 10:00 AM as it would help ensure that the cell sample collected is clear and adequate for accurate analysis by the pathologist.
For 48 hours before your test, please avoid:
- Intercourse as it can irritate the skin of the cervix, introduce bacteria, and inflame vaginal tissue.
- Douching
- Using any vaginal creams, suppositories, or vaginal medications
- Do not schedule a test on your period
If you have already had sex within 24-48 hours of your appointment, you should let your doctor know, as they may decide to reschedule or take this into account when analyzing your results.
You may experience very light spotting immediately after the test, but this is normal and should resolve quickly. You can resume all normal activities immediately.
How do I prepare for my semen analysis?
Day 1: Have sexual intercourse or masturbate.
Days 2–4: Abstain from sexual activity.
Day 5: Arrive at the facility before 9:00 AM for your test.
Important:
Please avoid alcohol, caffeine, and recreational drugs (e.g., cocaine, marijuana).
Stop all herbal medications.
Avoid any hormone medications prior to the test.
